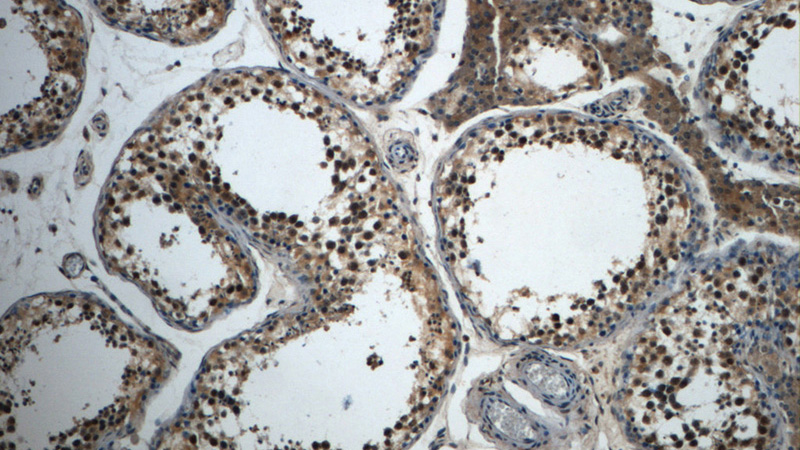
Immunohistochemistry of paraffin-embedded human testis slide using Catalog No:115980(TAF15 Antibody) at dilution of 1:50

-
Product Name
TAF15 antibody
- Documents
-
Description
TAF15 Rabbit Polyclonal antibody. Positive IHC detected in human testis tissue, human kidney tissue. Positive IF detected in HEK-293 cells. Positive WB detected in HEK-293 cells. Observed molecular weight by Western-blot: 68 kDa
-
Tested applications
ELISA, WB, IHC, IF
-
Species reactivity
Human; other species not tested.
-
Alternative names
hTAFII68 antibody; RBP56 antibody; RNA binding protein 56 antibody; TAF(II)68 antibody; TAF15 antibody; TAF2N antibody; TAFII68 antibody
-
Isotype
Rabbit IgG
-
Preparation
This antibody was obtained by immunization of TAF15 recombinant protein (Accession Number: NM_139215). Purification method: Antigen Affinity purified.
-
Clonality
Polyclonal
-
Formulation
PBS with 0.02% sodium azide and 50% glycerol pH 7.3.
-
Storage instructions
Store at -20℃. DO NOT ALIQUOT
-
Applications
Recommended Dilution:
WB: 1:500-1:5000
IHC: 1:20-1:200
IF: 1:20-1:200
-
Validations

HEK-293 cells were subjected to SDS PAGE followed by western blot with Catalog No:115980(TAF15 Antibody) at dilution of 1:1000
Immunohistochemistry of paraffin-embedded human testis slide using Catalog No:115980(TAF15 Antibody) at dilution of 1:50

Immunofluorescent analysis of (-20oc Ethanol) fixed HEK-293 cells using Catalog No:115980(TAF15 Antibody) at dilution of 1:50 and Alexa Fluor 488-congugated AffiniPure Goat Anti-Rabbit IgG(H+L)
-
Background
TAF15 (TAF2N or TAFII68) is a nuclear protein known to associate with a distinct subpopulation of transcription factor IID (TFIID), a multi-subunit complex that nucleates the pre-initiation complex on promoters of on protein-coding genes. TAF15 harbors a transcriptional activation domain, a RNA recognition motif and many Arg-Gly-Gly repeats that participate in RNA binding. TAF15 along with FUS and EWS constitutes the FET (FUS/EWS/TAF15) protein family of heterogeneous nuclear ribonucleoproteins (hnRNPs) class of RNA binding proteins that are multifunctional proteins implicated in numerous aspects of RNA processing/functions. TAF15 is a nuclear protein that shuttle between cytoplasm-nucleus and as RNA/ssDNA-binding protein, it play specific roles during transcription initiation at distinct promoters and enter the preinitiation complex together with the RNA polymerase II. TAF15 as well as other FET member genes are frequently translocated in sarcomas and rare hematopoietic as well as epithelial cancers. Moreover, dominant mutations in genes coding for four hnRNPs (TDP-43, FUS/TLS, TAF15, and EWS) are found in familial and sporadic cases of ALS and a chromosomal aberration involving TAF15/TAF2N is found in a form of extraskeletal myxoid chondrosarcomas (EMC).
Related Products / Services
Please note: All products are "FOR RESEARCH USE ONLY AND ARE NOT INTENDED FOR DIAGNOSTIC OR THERAPEUTIC USE"
